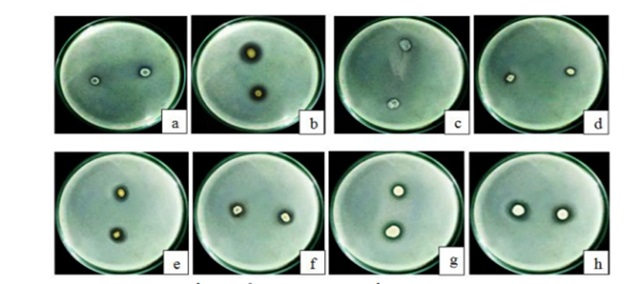
Vi khuẩn tại rễ sẽ giải phóng được P hữu cơ và tòa tan P vô cơ Vi khuẩn tại rễ sẽ giải phóng được P hữu cơ và tòa tan P vô cơ

Trồng Trọt, Tin tức
[Góc chia sẻ] Phân bón vi sinh chuyển hóa lân là gì?
Cũng giống như Nitơ hay Kali, Photpho trong phân lân sẽ ảnh trưởng đến sự phát triển của các loại cây trồng. Hiện nay, phân bón vi sinh chuyển hóa lân đang trở thành lựa chọn ưu tiên của nhiều nhà nông nhờ những công dụng vượt trội. Để giúp bạn hiểu rõ hơn về loại phân bón này, Chế phẩm vi sinh Đức Bình sẽ chia sẻ thông tin chi tiết và hữu ích sau đây.
1. Phân bón vi sinh chuyển hóa lân là gì?
1.1. Chuyển hóa lân ở môi trường đất

Đây là một quy trình vật lý và sinh học phức tạp, trong đó, các hợp chất photpho (vô cơ hoặc hữu cơ) được phân giải, hòa tan hoặc tổng hợp để chuyển đổi thành các dạng khoáng phosphate hoặc các hợp chất chứa P khác có khả năng cung cấp cho cây trồng.
1.2. Quy trình thực hiện chuyển hóa lân
Thực tế, có tới khoảng 95% lượng photpho ở dạng không hòa tan hoặc kết tủa trong đất mà thực vật không thể trực tiếp sử dụng được. Dưới tác động của các yếu tố vật lý như mưa và gió, phosphate sẽ được giải phóng, hòa tan và thấm xuống nguồn nước hoặc đất. Các ion phosphate này rất dễ tan và cây trồng có thể hấp thụ hoàn toàn qua rễ. Ngoài ra, chu trình chuyển hóa lân còn diễn ra khi động vật tiêu thụ thực vật và sau khi chúng chết đi, photpho sẽ được phân giải và tái trở lại môi trường đất.
Khoáng chất quan trọng của nguyên tố P ở trong đất là: hydroxyapatite, apatit, oxyapatite. Ngoài ra, P còn có thể liên kết cùng nguyên tố Mn, Fe hoặc Al để tạo thành hợp chất khó tan (đặc trung của loại đất feralit).
Vi sinh vật sẽ bắt đầu công việc chuyển đổi dạng lân vô cơ/hữu cơ thành HPO42- và H2PO4- để cây hấp thụ được (hay còn gọi là quy trình khoáng hóa).
1.3. Khái niệm về Phân bón vi sinh chuyển hóa lân
Phân vi sinh chuyển hóa lân (hay còn gọi là phân lân vi sinh) là loại phân bón có thành phần chính là các vi sinh vật có khả năng hỗ trợ hòa tan các hợp chất photpho (vô cơ hoặc hữu cơ) khó tan trong đất, chuyển hóa chúng thành các dạng khoáng chất dễ tiêu mà cây trồng có thể hấp thụ trực tiếp qua rễ.
2. Đâu là những loại vi sinh vật phân giải lân trong đất?
Để chuyển hóa nguồn lân khó tiêu trong đất thành dạng dễ hấp thụ cho cây trồng, cần có sự tham gia của nhiều nhóm vi sinh vật, cụ thể:
2.1. Vi khuẩn
Nhóm vi khuẩn ở rễ có khả năng hòa tan cũng như khoáng hóa photpho bằng cách sử dụng những enzym như Phytases, Phosphatases hay C-P Lyases. Một số tên vi khuẩn phân giải lân điển hình là: Beijerinckia, Arthrobacter, Bacillus,… Ngoài ra, những loại vi khuẩn ở rễ còn có năng lực giải phóng P hữu cơ và hòa tan P vô cơ.
2.2. Xạ khuẩn
Xạ khuẩn thường được đem vào nền nông nghiệp với mục đích chính là ức chế bệnh do nấm hoặc các loại vi khuẩn gây ra. Enzym do xạ khuẩn tiết ra sẽ thực hiện phân giải phân lân khó tan thành khoáng dễ tan, đồng thời làm giảm nồng độ pH của đất canh tác.
2.3. Vi nấm phân giải lân
Bên cạnh vi khuẩn, các vi nấm trong đất cũng đóng vai trò quan trọng trong việc hòa tan photpho. Các chủng vi nấm điển hình tham gia vào quá trình này bao gồm: Trichoderma và Penicillium sp.
2.4. Nấm rễ sống cộng sinh
Nấm ở mô rễ sẽ hấp thụ tất cả các dưỡng chất có trong mùn. Các sợi nấm sẽ tiến hành phân giải hợp chất photpho phức tạp thành dạng lân dễ hòa tan hơn. Ngoài ra, rễ còn có th liên kết với những sợi nấm này để hấp thụ photpho mà nấm đã chuyển hóa trước đó.
3.3 Cơ chế phân giải lân

Quả thực, phân bón vi sinh chuyển hóa lân là một yếu tố không thể thiếu trong quy trình chăm sóc cây trồng hiện đại. Vậy, cơ chế nào giúp các nhóm vi sinh vật (VSV) này chuyển hóa photpho, khiến cây trồng hấp thụ dưỡng chất này một cách dễ dàng hơn?
Có 3 cơ chế để các vi sinh vật phân giải lân, cụ thể là:
- Giảm pH ở đất: Vi sinh vật sẽ giải phóng proton hoặc sản sinh axit hữu cơ để làm giảm độ pH của đất, khi pH giảm thì độ hòa tan mới tăng lên.
- Cạnh tranh cùng photpho ở hợp chất photpho khó tan: các vi sinh vật sẽ hòa tan các hợp chất lân khó hòa tan, sau đó tạo thành các axit hữu cơ và vô cơ.
- Khoáng hóa: các vi sinh vật sẽ thực hiện hủy hợp chất photpho hữu cơ phức tạp sang dạng đơn giản để cây hấp thụ được tốt nhất.
4. Tổng hợp những công dụng tuyệt vời của phân lân vi sinh
Vai trò của phân lân đối với cây trồng là vô cùng quan trọng, nhưng điều gì khiến phân bón vi sinh chuyển hóa lân trở thành lựa chọn ưu việt hơn cả? Dưới đây là một số thông tin quan trọng:
4.1. Lân có đóng vai trò gì với cây trồng?
Vai trò của phân bón vi sinh chuyển hóa lân là tham gia vào nhiều quá trình trao đổi của cây, chẳng hạn như: chuyển hóa nhóm chất dinh dưỡng, chuyển hóa chất glucose hay quang hợp. Đồng thời, nguyên tố P còn góp phần làm tăng khả năng cố định của Nitơ ở trong nhóm cây họ đậu.
Photpho còn là thành phần chính trong nhiều hợp chất quan trọng như: ATP, axit nucleic và phospholipid. Nếu thiếu lân thì cây sẽ bị còi cọc, khả năng chống chịu kém, chồi và rễ không phát triển, năng suất thấp,…
4.2. Tác dụng mạnh mẽ của phân lân vi sinh lên cây trồng

Những công dụng lớn nhất của loại phân bón vi sinh chuyển hóa lân là:
- Đem đến nguồn lân dễ hấp thụ: phân có chứa vi sinh vật chuyển hóa lân từ không hòa tan sang dạng hòa tan. Điều này khiến cây trồng dễ hấp thụ được lân, cải thiện sự phát triển của cây.
- Tăng sức đề kháng: phân bón tăng cường sức khỏe của cây, tránh được những tác động từ môi trường (thiếu lân, bệnh, hạn hán, đất thiếu dưỡng chất,…).
- Cải thiện chất lượng cây: phân bón tăng cường hấp thụ dưỡng chất khác như kali, nitơ, vi lượng. Từ đó mà cây trồng được khỏe mạnh, quả to, hoa nở đều và lá tươi tốt.
- Hệ rễ phát triển: vi khuẩn trong phân bón sẽ tạo ra những chất kích thích đến sự phát triển của toàn bộ hệ rễ. Như vậy, cây có thể phát triển mạnh mẽ, tăng khả năng chống chịu trước điều kiện khó khăn của môi trường hay hấp thụ tốt dưỡng chất và nước.
- Cải thiện cấu trúc của đất canh tác: phân bón sẽ tạo ra những chất keo và chất hữu cơ để đất trở nên tơi xốp và màu mỡ. Làm như vậy thì cây trồng của bà con cũng được phát triển một cách tốt nhất.
- Thân thiện với môi trường sống: Thay vì dùng các loại phân hóa học thông thường, việc sử dụng phân vi sinh chuyển hóa lân sẽ không gây ra các vấn đề ô nhiễm môi trường. Thậm chí, loại phân bón này còn giúp duy trì cân bằng hệ sinh thái trong đất và hạn chế được tình trạng rò rit chất dinh dưỡng vào nguồn nước.
5. 2 Cách bón phân lân vi sinh cho cho cây trồng

Để phân bón có thể phát huy tốt những tác dụng trên, bà con có thể bón phân cho cây của mình theo 1 trong 2 cách sau:
- Trộn đều hạt giống cùng phân bón trước khi bắt đầu gieo trồng: Ở cách này, bà con cần phải làm ẩm hạt giống đã chuẩn bị bằng cách ngâm chúng với nước trong vài phút. Sau đó, bạn hãy trộn đều hạt giống đã ngâm cùng với phân lân vi sinh với tỷ lệ 100kg hạt x 1kg phân bón. Khi đã đợi đủ 10 đến 20 phút thì bạn đã có thể gieo hạt rồi.
- Bón trực tiếp phân vào đất canh tác: Khi phát hiện đất trồng vẫn còn đọng lại phân hóa học hoặc cây có biểu hiện của việc thiếu lân thì bà con nên bón phân trực tiếp vào đất. Đây là thời điểm quan trọng cần bón phân lân vi sinh ngay để vi sinh vật có thể phân giải chất photpho trong đất.
6. So sánh ưu điểm của phân lân vi sinh và phân lân hóa học
Phân lân vi sinh mang lại nhiều lợi ích vượt trội so với phân lân hóa học truyền thống, cụ thể:
| Đặc điểm | Phân lân vi sinh | Phân lân hóa học |
| Nguồn lân | Chuyển hóa lân khó tan thành dễ tan, tận dụng lân sẵn có trong đất. | Cung cấp lân dễ tan trực tiếp, nhưng dễ bị cố định lại thành khó tan. |
| Tác động đến đất | Cải tạo cấu trúc đất, tăng độ tơi xốp, thân thiện môi trường. | Dễ gây chua đất, thoái hóa đất nếu lạm dụng, nguy cơ ô nhiễm nguồn nước. |
| Vai trò khác | Cung cấp chất kích thích sinh trưởng, tăng sức đề kháng cho cây. | Chỉ cung cấp dưỡng chất P. |
| Hiệu quả | Hiệu quả bền vững, lâu dài, kích thích rễ phát triển mạnh. | Hiệu quả nhanh, nhưng dễ bị rửa trôi hoặc cố định nhanh chóng. |
7. Lưu ý khi sử dụng và bảo quản phân lân vi sinh
Để phân lân vi sinh đạt hiệu quả cao nhất, người nông dân cần chú ý:
- Tránh dùng chung với thuốc diệt nấm hoặc hóa chất mạnh: Vì phân lân vi sinh chứa vi sinh vật sống, việc dùng chung với các hóa chất có thể làm giảm hoặc tiêu diệt hoạt tính của chúng.
- Bảo quản nơi khô ráo, thoáng mát: Không để phân tiếp xúc trực tiếp với ánh nắng mặt trời hay nhiệt độ cao, điều này giúp duy trì số lượng và chất lượng của vi sinh vật.
- Sử dụng đúng liều lượng: Tuân thủ hướng dẫn của nhà sản xuất để đảm bảo vi sinh vật có đủ mật độ cần thiết để phân giải lân hiệu quả trong đất.
Phân bón vi sinh chuyển hóa lân là loại phân được nông dân tin tưởng khi cây trồng phát triển tốt và năng suất tăng. Hy vọng bài viết hữu ích và đừng ngần ngại liên hệ với Chế phẩm vi sinh Đức Bình để tìm hiểu một số loại men vi sinh tốt cho cây trồng nhé!
⫸ Xem thêm: Cách sử dụng phân đạm hiệu quả trong nông nghiệp hiện đại
⫸ Xem thêm: Phân vi sinh là gì? Đặc điểm, công dụng và cách sử dụng hiệu quả
Thông tin liên hệ
Chế phẩm vi sinh Đức Bình – Trung tâm nghiên cứu và ứng dụng chế phẩm sinh học chuyên nghiên cứu, sản xuất và ứng dụng các dòng sản phẩm: Men vi sinh, men bể phốt, men xử lý nước thải, men thuỷ sản, chế phẩm sinh …
Địa chỉ : 1B Ngõ 774 Kim Giang, Thanh Liệt, Hà Nội
SĐT: 0934.214.579
Hotline: 024.66.55.46.86
Email: chephamvisinhungdung@gmail.com
Website: https://webvisinh-mai.webmanhan.com
